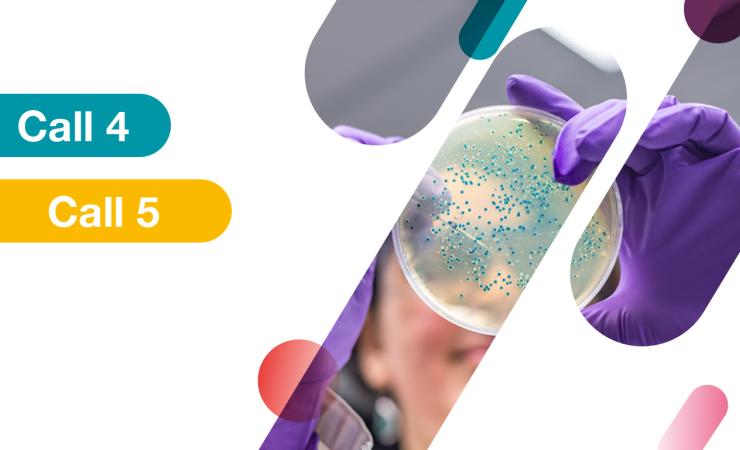
Banner Call4-5 (without logo)

Our new interview of Pr. Pierre Emmanuel Gleizes – RIBOEUROPE: The European Ribosomopathy Consortium!
Watch the insightful interview with Pr. Pierre-Emmanuel Gleizes, Coordinator of RIBOEUROPE: The European Ribosomopathy Consortium. Funded by the European Joint Programme on Rare Diseases (EJP RD), Pierre-Emmanuel Gleizes sheds light on the remarkable work his team is doing to combat a rare disease and the tremendous potential of European collaboration in achieving their goals. More…
Détails